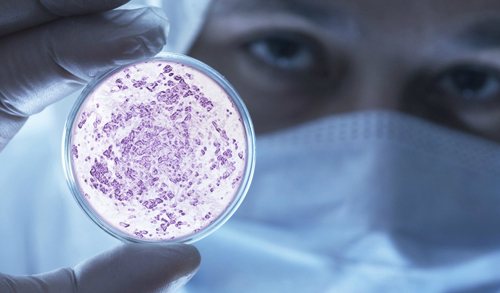
Кишечная палочка

Гемолитическая (гемолизирующая) кишечная палочка – это один из представителей условно-патогенной флоры человеческого организма. Обитает на слизистых оболочках пищеварительного канала, репродуктивной сферы мужчины и женщины, мочеполового тракта. Серьезные повреждения может нанести только в том случае, если организм человека находится в состоянии выраженного иммунодефицита.
Что такое E. coli
Чтобы было понятно, о чем пойдет речь в статье, объясним наименование микроорганизмов — E. coli лактозонегативные. По-другому их называют кишечными палочками, потому что они живут в кишечнике людей и некоторых видов млекопитающих. На латыни это звучит как Escherichia coli. Название «эшерихии» дано микроорганизмам в честь ученого из Австрии Теодора Эшериха, который первым их обнаружил.
Термин «лактозо» означает, что они хорошо размножаются на лактозе, то есть в молочных средах, а «негативные» подчеркивает их вредную для организма человека деятельность. В группе E. coli, кроме лактозонегативных, выделяют энтерогеморрагические, энтероинвазивные, энтеротоксигенные и энтеропатогенные кишечные палочки. Для здоровья опасно любое их количество в кишечнике.
Микроскоп позволяет увидеть, как они выглядят. E. coli лактозонегативные и другие эшерихии действительно похожи на короткие палочки с округлыми концами. Шириной они до 0,8 мкм, длиной до 3 мкм. Иногда эти бактерии концами соединяются друг с другом, образуя цепочки. Снаружи их оболочка покрыта пилями — ворсинками, помогающими микробу закрепляться на стенках кишечника и быть нечувствительными ко многим антибиотикам.
Лактозонегативные E. coli являются факультативными анаэробами, то есть для их жизнедеятельности кислород не нужен, но его присутствие они переносят без труда.
Эти бактерии, как и все эшерихии, имеют множество штаммов, различающихся между собой некоторыми внешними признаками, реакцией на антибиотики, выделяемыми токсинами и другими особенностями.

Лактозонегативные энтеробактерии представляют собой группу бактерий, которые могут вызывать различные заболевания, особенно в кишечнике. Врачи отмечают, что повышение уровня этих микроорганизмов может быть связано с несколькими факторами, включая нарушения в питании, стресс, а также хронические заболевания желудочно-кишечного тракта. Важно понимать, что наличие лактозонегативных энтеробактерий не всегда свидетельствует о болезни, однако их избыток может указывать на дисбаланс микрофлоры.
Лечение, по мнению специалистов, должно быть комплексным и включать как коррекцию диеты, так и применение пробиотиков для восстановления нормальной микрофлоры. В некоторых случаях может потребоваться антибиотикотерапия, но ее назначение должно быть обоснованным и контролируемым. Врачи подчеркивают важность своевременной диагностики и индивидуального подхода к каждому пациенту, чтобы избежать осложнений и восстановить здоровье.

Профилактика
Профилактические мероприятия включают в себя:
- неукоснительное соблюдение санитарно-гигиенических правил, поскольку заражение в основном происходит орально-фекальным путём;
- правильное сбалансированное питание;
- регулярное употребление кисломолочных продуктов, которые способствуют созданию «живой» кишечной микрофлоры, полезной для здоровья.
Чтобы не спровоцировать всплеск активности палочки, нельзя без рекомендаций врача принимать какие-либо антибиотики, потому что они могут нарушить баланс кишечной микрофлоры.
Чтобы оградить себя и своего полового партнёра от инфекционных воспалений, вызванных палочкой, лучший способ – избегать беспорядочных связей и пользоваться средствами предохранения.
Но следует знать и то, что чрезмерное увлечение санитарно-гигиеническими процедурами приводит к нарушению микрофлоры – очистительные клизмы вымывают полезные микроорганизмы, а частое спринцевание с применением антисептиков уничтожает естественную микрофлору и открывает путь бактериальной инфекции.
Кишечные палочки у женщин
Если у женщин E. coli лактозонегативные повышены в кале, диагностируется дисбактериоз II степени. Вызвать его могут:
- тяжелые заболевания любой этиологии, приведшие к снижению иммунитета;
- бесконтрольный или длительный прием антибиотиков.
Попадание в кишечник других патогенных E. coli возможно в таких ситуациях:
- употребление некачественной воды и пищи;
- телесный контакт (например, рукопожатие) с носителем бактерии;
- несоблюдение гигиены;
- пользование предметами обихода, на которых имеются кишечные палочки (надо заметить, что они во внешней среде очень живучи, подолгу могут существовать в почве, в продуктах питания и в воде).
В большинстве случаев заболевание проходит без приема антибиотиков. Методы лечения:
- жесткая диета;
- обильное питье;
- прием энтеросорбентов.
Гораздо опаснее, если обнаружены лактозонегативные E. coli в моче или во влагалище, потому что в норме их там быть не должно. Попадают бактерии в несвойственную им среду при неправильной гигиене или ее отсутствии (без регулярного подмывания кишечные палочки, вышедшие из толстой кишки с каловыми массами, остаются на теле и проникают во влагалище), при ношении тесного белья, особенно стрингов, при незащищенном половом акте с носителем бактерии.
Если во влагалище обнаружена E. coli лактозонегативная, как лечить такое заболевание? И обязательно ли это делать, если женщина не чувствует дискомфорта? Кишечные палочки, попав в половые органы, могут переместиться оттуда в уретру, мочевой пузырь, яичники, матку. Струей мочи они не вымываются и практически всегда вызывают воспаление, которое без должного лечения переходит в хроническую форму.
То есть женщина становится носительницей E. coli. При этом явные симптомы могут отсутствовать, наблюдаются только выделения из влагалища с характерным неприятным запахом и некоторый дискомфорт во время полового акта. Переохлаждение, стресс, плохое питание, любое заболевание могут спровоцировать переход хронической формы в острую, поэтому если анализ показал наличие во влагалище лактозонегативных E.
Лактозонегативные энтеробактерии представляют собой группу бактерий, которые не способны ферментировать лактозу. Их повышенное содержание в организме может свидетельствовать о различных нарушениях, таких как дисбактериоз или инфекции. Люди часто отмечают, что симптомы, связанные с повышением этих бактерий, могут включать боли в животе, диарею и вздутие. Причинами такого состояния могут быть неправильное питание, стресс или длительное применение антибиотиков, которые нарушают баланс микрофлоры. Лечение обычно включает коррекцию рациона, применение пробиотиков и, в некоторых случаях, антибиотиков для устранения инфекции. Важно обратиться к врачу для диагностики и назначения адекватной терапии, так как самостоятельное лечение может усугубить ситуацию.

Профилактические мероприятия
Профилактические мероприятия направлены на возобновление и поддержку микрофлоры с помощью диеты и лечения побочных болезней.
Каких правил следует придерживаться
При попадании кишечной палочки во влагалище у женщин появляется вагинальный дисбактериоз.
Устранению патологии способствуют:
- Дозированное употребление антибактериальных препаратов. Их применяют только с позволения врача. В обратном случае повредите микрофлору.
- Исключение вредных продуктов питания и спиртного. Копчёности, маринованные продукты, пряная пища, алкоголь вызывает гибель микрофлоры.
- Диагностика и лечение побочных заболеваний способствуют возобновлению микрофлоры.
- При дисбактериозе необходимо правильно питаться.
- К бактериозу приводит несоблюдение гигиены. Злоупотребление процедурами не способствует сохранению микрофлоры. Частые спринцевания, клизмы с добавлением антисептических средств разрушают флору кишечника и половой сферы. Её отсутствие обнаруживается при взятии мазков в результате обследования у гинеколога, при сдаче кала на анализ. Для её возобновления назначаются пробиотики, вагинальные свечи.
Кишечные палочки у мужчин
Лактозонегативные E coli повышены у взрослого мужчины в кале? Если показатели отличаются от нормы — это свидетельствует о дисбактериозе. Причины его возникновения, симптомы и методы лечения — такие же, как для женщин. Попадание кишечных бактерий в уретру полового органа мужчины вызывает уретрит, который может протекать в острой форме (с сильными болевыми ощущениями при мочеиспускании) всего один-два дня, а далее без лечения перейти в хроническую.
Бактерии из уретры мигрируют в половые органы и провоцируют такие болезни, как простатит, орхит (воспаление яичек), эпидидимит (воспаление придатков семенников). Переходить из хронической в острую форму заболевания будут при переохлаждениях, стрессах, любых ситуациях, влекущих снижение иммунитета. Поэтому лечение (лактозонегативной E. coli в мочеполовых органах мужчины быть не должно!) обязательно. Проводят его по той же схеме, что и у женщин.
Методы лечения
При подозрении инфицирования детей до года нужно сразу вызывать неотложку, поскольку помочь новорожденному, если его организм заселила гемолитическая кишечная палочка, можно только в условиях стационара. Педиатры обязательно возьмут анализы — кровь, мочу, кал и образцы рвоты.
Детей старше года можно с успехом лечить дома по такой схеме:
- Проводить антибактериальную терапию. Лучшим средством является сироп “Нифуроксазид”, предназначенный для лечения острых кишечных инфекций. Принимать его нужно 5-7 дней в дозировке согласно инструкции по возрасту ребенка.
- Отпаивать ребенка большим количеством жидкости (1-1,5 литра в сутки), приготовленной из специальных препаратов для пероральной регидрации — “Регидрон”, “Гидровит”, “Хумана Электролит”, “Маратоник”, “Гастролит”, “Орсоль”. ВОЗ дает рекомендации по приготовлению подобного раствора в домашних условиях: по 1 чайной ложке поваренной соли и соды, 1 столовая ложка сахара на 1 литр воды.
- Очищать организм от токсинов, так как кишечная палочка у грудничка способна вызвать сильную интоксикацию. Самые эффективные сорбенты — “Энтеросгель”, “”Полисорб”, “Бактистатин”, “Смекта”, “”Сорбекс”, “Сорболонг”. Способ применения и дозы подробно описаны в инструкции к препарату.
- Помогать перевариванию и усвоению пищи. При заражении кишечной палочкой часто развивается ферментная недостаточность, поэтому с едой рекомендуется давать малышу ферменты для улучшения пищеварения — “Мезим”, “Панкреатин”, “Креон”. Последний препарат многие педиатры считают лучшим.
- Восстановить нормальную микрофлору кишечника. Справиться с этой задачей помогут пробиотики и пребиотики. Пробиотики — это готовые живые микроорганизмы, которые в норме населяют кишечник человека, а пребиотики — химические соединения, которые создают благоприятную микрофлору для роста и размножения полезных бактерий. Первую неделю рекомендуется давать ребенку пробиотики — “Линекс”, “Лактобактерин”, “Лактимак”, “Энтерол”, “Бифиформ”. Вторую неделю желательно перейти на пребиотики — “Лактофильтрум”, “Гудлак”, “Дюфалак”, “Лизалак”, “”Фервитал”. Кстати, грудное молоко само по себе является уникальным природным пребиотиком, помогающим всего за 1-2 дня восстановить микрофлору кишечника, поэтому данный пункт при лечении детей на грудном вскармливании можно пропустить.
Соблюдать диету в течение двух недель, чтобы не давать лишней нагрузки печени и поджелудочной железе: кашки и супчики варить на воде, избегать жирной пищи, ограничить мясо, молоко и яйца, исключить сырые овощи, фрукты и соки.
При такой терапии даже без антибиотиков ребенку должно стать значительно лучше уже на 3-й день лечения, а на 5-й день в 90% случаев наступает выздоровление. Следующие 2 недели рекомендовано поберечь организм и всячески способствовать восстановлению иммунитета.
При подозрении инфицирования детей до года нужно сразу вызывать неотложку, поскольку помочь новорожденному, если его организм заселила гемолитическая кишечная палочка, можно только в условиях стационара. Педиатры обязательно возьмут анализы – кровь, мочу, кал и образцы рвоты.
Если в кале у грудничка будет обнаружено большое количество патогенного штамма, врачи проведут необходимую терапию, введут внутривенно и внутримышечно лекарства, восполнят потери жидкости и минеральных солей
- Проводить антибактериальную терапию. Лучшим средством является сироп “Нифуроксазид”, предназначенный для лечения острых кишечных инфекций. Принимать его нужно 5-7 дней в дозировке согласно инструкции по возрасту ребенка.
- Отпаивать ребенка большим количеством жидкости (1-1,5 литра в сутки), приготовленной из специальных препаратов для пероральной регидрации – “Регидрон”, “Гидровит”, “Хумана Электролит”, “Маратоник”, “Гастролит”, “Орсоль”. ВОЗ дает рекомендации по приготовлению подобного раствора в домашних условиях: по 1 чайной ложке поваренной соли и соды, 1 столовая ложка сахара на 1 литр воды.
- Очищать организм от токсинов, так как кишечная палочка у грудничка способна вызвать сильную интоксикацию. Самые эффективные сорбенты – “Энтеросгель”, “”Полисорб”, “Бактистатин”, “Смекта”, “”Сорбекс”, “Сорболонг”. Способ применения и дозы подробно описаны в инструкции к препарату.
- Помогать перевариванию и усвоению пищи. При заражении кишечной палочкой часто развивается ферментная недостаточность, поэтому с едой рекомендуется давать малышу ферменты для улучшения пищеварения – “Мезим”, “Панкреатин”, “Креон”. Последний препарат многие педиатры считают лучшим.
- Восстановить нормальную микрофлору кишечника. Справиться с этой задачей помогут пробиотики и пребиотики. Пробиотики – это готовые живые микроорганизмы, которые в норме населяют кишечник человека, а пребиотики – химические соединения, которые создают благоприятную микрофлору для роста и размножения полезных бактерий. Первую неделю рекомендуется давать ребенку пробиотики – “Линекс”, “Лактобактерин”, “Лактимак”, “Энтерол”, “Бифиформ”. Вторую неделю желательно перейти на пребиотики – “Лактофильтрум”, “Гудлак”, “Дюфалак”, “Лизалак”, “”Фервитал”. Кстати, грудное молоко само по себе является уникальным природным пребиотиком, помогающим всего за 1-2 дня восстановить микрофлору кишечника, поэтому данный пункт при лечении детей на грудном вскармливании можно пропустить.
Соблюдать диету в течение двух недель, чтобы не давать лишней нагрузки печени и поджелудочной железе: кашки и супчики варить на воде, избегать жирной пищи, ограничить мясо, молоко и яйца, исключить сырые овощи, фрукты и соки.
| Препарат | Фото | Цена |
| Ципрофлоксацин | от 21 руб. | |
| Левофлоксацин | от 133 руб. | |
| Фурацилин | от 101 руб. | |
| Амоксициллин | от 41 руб. |
При заболеваниях урогенитальной сферы, спровоцированных лактозонегативной кишечной палочкой, диетологи прописывают больным лечебный стол №7. Это диета, применяемая при лечении почечных заболеваний, ограничивает употребление соли, острой и тяжёлой жирной пищи.
При установленном дисбактериозе назначается диета №4, исключающая трудно перевариваемую пищу и рекомендующая специальные молочные продукты, в частности, ацидофильное молоко и кальцинированный творог. Обе лечебные диеты приветствуют приготовление продуктов на пару, а в качестве первых блюд используют слизистые протёртые супы на воде, овощном отваре или нежирном бульоне из птицы.
Такое питание способствует восстановлению нормальной кишечной микрофлоры и регулированию показателей лактозонегативной палочки. Чтобы лечение было более эффективным, терапия дополняется Ациполом, Лактобактерином и т. п.
При значительном обезвоживании в результате диареи применяется лечение Гидровитом и Регидроном, их инфузионное применение восстанавливает состав крови. Эти капельницы абсолютно безвредны, их назначают даже беременным и кормящим.
Применение антибиотикотерапии должно проходить под врачебным контролем, поскольку кишечная микрофлора может выработать резистентность к применяемым антибиотикам. Если промежуточные анализы снова покажут рост лактозонегативной бактерии, нужно вносить изменения в схему лечения.
Если речь идёт о заболеваниях урогенитальной сферы, пациентам рекомендуется воздержаться от сексуальных контактов до полного излечения.
При подозрении на расстройство работы кишечника у детей берут анализы кала на дисбактериоз и копрограмму. Собирать материал для анализа лучше с пеленки, а не с подгузника.
Если анализы показали, что лактозонегативные E. coli повышены у грудничка, но его состояние нормальное, лечение не проводится. В отдельных случаях врач назначает пробиотики, например «Бифидумбактерин», и пребиотики, такие как «Хилак-Форте», «Дюфалак».
Если состояние ребенка до года тяжелое, его обязательно госпитализируют. В больнице проводится комплексная терапия, направленная на недопущение обезвоживания (маленьким детям ставят капельницы с регидратационными растворами) и на снижение показателей кишечной палочки.
Если наблюдается избыточная пролиферация кишечной палочки, и у ребенка развился менингит или другие тяжелые осложнения, лечение проводят антибиотиками.
В случаях обнаружения в кале младенца патогенных кишечных палочек, лечение обязательно. Оно проводится антибиотиками, регидратационными растворами, пробиотиками и пребиотиками.
При наличии у ребенка поноса и других симптомов нарушения работы органов ЖКТ, необходимо сдать анализы:
- копрограмму;
- кал на дисбактериоз.
Иногда выполняют бакпосев мочи и рвотных масс на наличие в материале кишечных палочек.
Энтерогеморрагические палочки в результатах анализов должны отсутствовать. E. coli лактозонегативные в кале у детей старше года и взрослых должны оставаться в пределах 10*5 КОЕ/г. При этом в целом всех условно-патогенных E. coli должно быть от 10*7 до 10*8 КОЕ/г. Если этот показатель уменьшен до значений 10*6 КОЕ/г, диагностируют дисбактериоз I степени, а если увеличен до 10*9 КОЕ/г и выше — дисбактериоз II степени.
Лечение при повышенных лактозонегативных E. coli основывается на строгой диете. Она включает каши, сваренные на воде без масла, слизистые супы (рисовые, овсяные), отварные рыбу, овощи, мясо, а также сухарики, баранки, черный хлеб. Чтобы избежать обезвоживания, ребенку дают частое питье (чистую воду, чаи с ромашкой, тысячелистником), кисели, приготовленные из яблок, черной смородины, компоты из сухофруктов.
Если дисбактериоз сопровождается температурой от 38 °C, назначают жаропонижающие препараты.
Если лечение не приносит результатов на 4-й день, больному прописываются антибиотики. Эффективными считаются «Ципрофлоксацин», «Амоксициллин».
После выздоровления пациенты обязательно пропивают курс пробиотиков «Бифидумбактерин», «Линекс», «Бификол» и другие.
Нормы содержания в кале
В обычных лабораториях указывается общее количество и число колоний, подробный подсчет выполняют только специализированные учреждения.
Нормальные значения такие:
- лактозонегативные энтеробактерии – менее 5%;
- патогенные энтеробактерии – отсутствуют;
- клебсиелла – менее или до 104;
- протей – до 104;
- серрации – до 104;
- гафнии – до 104;
- морганеллы – до 104;
- провиденции – до 104;
- цитробактеры – до 104;
- энтеробактеры – до 104.
Нормальной считается концентрация бациллы лактозонегативного вида – не более 10*5 КОЕ/г. Показатель, превышающий указанную цифру или находящийся на этом уровне указывает на развивающийся дисбактериоз. Представителей гемолитических бактериальных штаммов не должно быть более 0, а штаммы с нормальной ферментацией в норме не должны превышать концентрацию от 10*6 до 10*8 КОЕ/г.
Пути заражения
При попадании в организм патогенного штамма в большом количестве нужно ждать беды. Особенно опасна гемолизирующая кишечная палочка у грудничка. В 99% случаев она попадает в кишечник извне – через зараженные бытовые предметы, пищу, руки. Не зря кишечные инфекции в народе называют “болезнью грязных рук”.
Невнимательное отношение родителей к чистоте посуды, игрушек, стерилизации бутылочек, сосок, несвоевременная уборка дома, немытые овощи, фрукты и зелень с рынка, мясо, рыба и морепродукты без должной термической обработки или с нарушением технологии хранения, кондитерские изделия – все это может стать источником заражения.
Хотя иногда даже у самых чистоплотных, аккуратных и ответственных мам и пап кишечная инфекция может поразить грудного ребенка. Дело в том, что патогенная гемолитическая кишечная палочка имеет очень высокую контагиозность и любой носитель (человек или животное) может стать причиной ее распространения, например, через физический контакт (поцелуй, недоеденный кусок, пользование одной посудой). Большую опасность представляет также некачественно очищенная питьевая вода.
Попадание в кишечник небольшого количества гемолитической кишечной палочки для взрослого здорового человека неопасно – проходя через желудочно-кишечный тракт, она в основном будет обезврежена желудочным соком, так как погибает в кислой среде. Но для новорожденного ребенка с несовершенной иммунной системой ситуация может быть очень опасной, вплоть до осложнений и летального исхода.
Другие факторы, которые могут стать пусковым механизмом для патогенных бактерий: переохлаждение, частые простудные заболевания, ослабленное здоровье, врожденные патологии.
Начинает неконтролируемо размножаться кишечная палочка у грудничка и при лечении антибиотиками без сопутствующего приема лакто- и бифидобактерий. Правильно рассчитать их дозы с учетом веса и возраста грудничка может только педиатр.
При попадании в организм патогенного штамма в большом количестве нужно ждать беды. Особенно опасна гемолизирующая кишечная палочка у грудничка. В 99% случаев она попадает в кишечник извне — через зараженные бытовые предметы, пищу, руки. Не зря кишечные инфекции в народе называют “болезнью грязных рук”.
Невнимательное отношение родителей к чистоте посуды, игрушек, стерилизации бутылочек, сосок, несвоевременная уборка дома, немытые овощи, фрукты и зелень с рынка, мясо, рыба и морепродукты без должной термической обработки или с нарушением технологии хранения, кондитерские изделия — все это может стать источником заражения.
Хотя иногда даже у самых чистоплотных, аккуратных и ответственных мам и пап кишечная инфекция может поразить грудного ребенка. Дело в том, что патогенная гемолитическая кишечная палочка имеет очень высокую контагиозность и любой носитель (человек или животное) может стать причиной ее распространения, например, через физический контакт (поцелуй, недоеденный кусок, пользование одной посудой). Большую опасность представляет также некачественно очищенная питьевая вода.
Попадание в кишечник небольшого количества гемолитической кишечной палочки для взрослого здорового человека неопасно — проходя через желудочно-кишечный тракт, она в основном будет обезврежена желудочным соком, так как погибает в кислой среде. Но для новорожденного ребенка с несовершенной иммунной системой ситуация может быть очень опасной, вплоть до осложнений и летального исхода.
Начинает неконтролируемо размножаться кишечная палочка у грудничка и при лечении антибиотиками без сопутствующего приема лакто- и бифидобактерий. Правильно рассчитать их дозы с учетом веса и возраста грудничка может только педиатр.
Как образуется патология?
Штаммы энтеробактерии, в своем большинстве, причиняют вред патогенной микрофлоре кишечника, синтезируют витамин К. Отдельные штаммы – источники появления у человека энтероколитов, дисбактериозов, колибактериозов.
Гнилостные и бродильные процессы начинаются при изменении соотношения между энтеробактериями и кокковыми формами (стрептококки, энтерококки и пр.). Отдельные штаммы лактозонегативной бациллы провоцируют развитие менингиальной инфекции у новорожденных и грудных детей, воспаления предстательной железы у мужчин, воспаления мочевого пузыря и других органов мочевыделительной системы, органов половой системы (воспаление влагалищной слизистой), патологии органов пищеварительного тракта.
Источники возникновения патологий в виде дисбактериоза, расстройств пищеварения и превышения нормы содержания кишечной лактозонегативной палочки могут быть разными, но проявления заболеваний пищеварительной системы, вызываемой ими, часто имеют сходных характер. Нередко дисбактериоз развивается по причине употребления антибиотиков, подавляющих развитие не только патогенных микроорганизмов, но и бактериальных форм, сдерживающих размножение болезнетворных бактерий.
Источником развития патологии нередко является больной человек с выделяемыми фекалиями, вследствие чего здоровый человек оральным путем, при несоблюдении мер личной гигиены, может приобрести большую дозу патогенных микроорганизмов. Личный контакт между инфицированным и здоровым человеком необязателен, распространению патогенной микрофлоры способствует употребление молока и мяса, подвергшимся недостаточной тепловой обработке, немытых овощей и фруктов, приготовление пищи с грубыми нарушениями технологии.
Различные виды условно-патогенных энтеробактерий
К таким микроорганизмам, помимо протея и клебсиеллы, относятся энтеробактер, цитробактер и другие виды энтеробактерий. Свойством всех их является снижение иммунных функций организма, что приводит к нарушению работы кишечника. Результатом этих процессов становятся воспаления и поражения различных органов.
Бактероиды
Они присутствуют в кишечнике человека в норме и относятся к группе условно-патогенных бактерий. Появляются в пищеварительном тракте эти микроорганизмы постепенно. У маленьких детей, не достигших полугодовалого возраста, обычно при анализе кала на дисбактериоз бактероиды не выявляются. У более старших детей до 2 лет, количество их не должно быть более 108 кое/г.
На сегодняшний день значение бактероидов полностью не выяснено. Но известно, что эти микроорганизмы необходимы для нормального течения процессов пищеварения, они участвуют в липидном обмене и расщеплении желчных кислот.
Стафилококки
Стафилококки могут присутствовать в кишечнике в норме, однако, это не относится к негемолитическим формам бактерий. Большинство типов стафилококков принадлежат к условно-патогенной группе микроорганизмов. Они являются сапрофитами и попадают в организм человека из окружающего мира. При анализе кала на дисбактериоз максимальным показателем по стафилококкам считается 104 кое/г.
Патогенные качества золотистого стафилококка напрямую зависят от состава микрофлоры кишечника. Чем больше здесь присутствует бифидо- и лактобактерий, а также кишечной палочки нормальной формы, тем меньше проявляется воздействие золотистого стафилококка.
Для дисбактериоза, причиной развития которого стал стафилококк, характерны симптомы, связанные с общей интоксикацией и воспалительным поражением кишечника. При таком состоянии у больного может наблюдаться подъем температуры (она может достигать отметки в 39 градусов, а иногда и выше), головная боль, потливость, слабость, озноб, нарушение аппетита и сна, постоянные или приступообразные боли в животе, а также обильный жидкий стул, в котором могут присутствовать примеси в виде слизи или крови.
С помощью лабораторных исследований можно отследить изменение состава крови. Для заболевания, вызванного золотистым стафилококком характерно повышение СОЭ, рост числа лейкоцитов, вместе с этим происходит сдвиг лейкоцитарной формулы влево, снижение альбуминовых фракций одновременно с повышением глобулиновых. В наиболее тяжелых случаях отмечается общее снижение количества белка, до 6,1 г/л.
Поэтому если при проведении анализа кала на дисбактериоз выявляется присутствие золотистого стафилококка, то необходима госпитализация больного.
Симптомы
Установить самостоятельно, что возбудителем инфекции является какая-то энтеробактерия, невозможно. Поэтому всегда нужно обращаться к педиатру, если состояние малыша изменилось. Обращать внимание нужно на такие признаки:
- беспокойство и постоянный плач;
- отказ от еды;
- частый стул или запор;
- изменение характера испражнений – водянистые, зловонные, примесь слизи, крови или зелени;
- повышение температуры тела;
- плач при мочеиспускании;
- изменение запаха мочи;
- рвота и тошнота;
- покраснение глаз;
- затрудненное дыхание или кашель;
- снижение общей активности;
- чрезмерная сонливость или долгое возбуждение.
Помимо лактозонегативной бациллы, в человеческом кишечнике обитают другие прокариоты (бациллы с нормальной ферментацией и палочки гемолизирующего типа), количество которых проверяется диагностическими методами. Проявлениями негативного воздействия лактозонегативных штаммов рассматривается патологический процесс дисбактериоза, первым и типичным признаком которого является диарея.
Патологический процесс развивается вне зависимости от возраста или пола человека, ему подвержены и младенцы. Диарею обычно сопровождают боли в животе, изменение запаха каловых масс, тошнота и рвота. Даже запах изо рта сопровождается изменением, характерным для расстройств пищеварительной системы. Кроме специфических симптомов, указывающих на дисбактериоз, в организме человека появляется ряд общих признаков заболевания: повышенная утомляемость, вялость, склонность ко сну, отказ от пищи, недомогание.
Симптоматика коли-инфекции у грудничка
Основной путь передачи палочки – фекально-оральный. Гемолизирующая кишечная палочка может попасть в организм ребенка, например, вместе с молоком матери, либо быть получена в период пребывания в стенах родильного отделения.
Причины размножения кишечной палочки могут быть разными, но чаще всего – это снижение иммунной защиты малыша. Но переносчиками инфекции также могут оказаться и ручки ребенка, которые он постоянно тянет в рот, упавшая на пол соска или некачественно продезинфицированная бутылочка.
Активное размножение кишечной палочки становится причиной формирования дисбаланса микрофлоры ЖКТ новорожденного. Малыш становится беспокойным, плохо спит. Как правило, на фоне качественного перераспределения бактериального состава кишечника у ребенка появляются колики – боли в животике, носящие приступообразный характер, и появляющиеся всегда после кормления.
Симптомы коли-инфекции могут быть достаточно разнообразными. И вот самые основные:
- вздутие живота и повышенное образование газов;
- урчание в кишечнике;
- нарушение прохождения пищи по ЖКТ становится причиной активного срыгивания и даже рвоты;
- иногда диагностируется синдром мальабсорбции (нарушение всасываемости поверхностью тонкого кишечника питательных веществ);
- понос (кал становится пенистым и сопровождается гнилостным либо кислым запахом);
- малыш начинает терять в весе.
При слишком сильной диарее у малыша развивается обезвоживание. Симптомы этого состояния следующие:
- сухость языка и кожного покрова;
- редкое мочеиспускание;
- слабость;
- сонливость;
- повышение общей температуры (редко).
Лактозонегативная кишечная палочка входит в список условно-патогенных бактерий. И в небольшом объеме – не больше 5% от общей микрофлоры – постоянно присутствует в кишечном тракте малыша. При этом она отвечает за многие процессы:
- отвечает за производство витаминов группы В и К;
- обеспечивает полноценное усвоение железа и кальция;
- принимает участие в обменных процессах.
Превышение допустимой нормы лактозонегативной кишечной палочки проявляется как:
- усиленное газообразование;
- частые срыгивания;
- чередование запора/поноса;
- присутствие в составе кала частичек непереваренной пищи (если малыш уже получает прикорм);
- болями в животе.
Повышение общего числа лактозонегативной кишечной палочки медиками как серьезное нарушение не рассматривается. Лечение в этом случае заключается в приеме препаратов, содержащих пробиотики («Бифидумбактерин», «Колибактерин» и т.д.) и пребиотики («Дюфалак», «Хилак-форте» и т.д.).
Не стоит забывать, что основная причина роста кишечной палочки – низкая иммунная защита, поэтому педиатры настоятельно рекомендуют не прекращать грудного вскармливания как минимум до исполнения ребенку одного года. Ведь именно грудное молоко – неистощимый источник лактозы, которая и является поставщиком полезной для детского кишечника микрофлоры.
Если грудное вскармливание по каким-либо причинам невозможно, необходимо использовать смеси, содержащие в составе пребиотики. Помочь с выбором сможет наблюдающий малыша педиатр.
В процессе приема препаратов необходимо сдавать промежуточные анализы. Это дает возможность контролировать ход терапии.
Если у грудничка появились симптомы нарушения работы пищеварительной системы – особенно это касается поноса и рвоты – то крайне важно в самое ближайшее время получить квалифицированную медицинскую помощь. Самостоятельное лечение может стать причиной серьезных последствий для малыша.
Среди патологических состояний человека наиболее опасными могут быть заболевания, вызванные кишечной палочкой. Они приводят к тяжелым осложнениям, иногда пожизненным, вплоть до летального исхода. В зоне риска преимущественно находятся лица с ослабленным иммунитетом, в том числе грудные дети, беременные, пожилые люди (старше 60 лет).
В нормальном состоянии у младенцев в кишечнике обязательно должны присутствовать полезные бактерии. Если лактозонегативные E. coli повышены, у грудничка может начаться дисбактериоз. Это происходит по причине низкого иммунитета у новорожденных деток и неспособности их организма контролировать численность бактерий. Признаки заболевания:
- вздутие животика;
- метеоризм;
- частые срыгивания, иногда рвота;
- урчание в животе;
- диарея (кал водянистый, пенистый, с характерным запахом);
- аллергический дерматит;
- потеря в весе.
В кале могут наблюдаться непереваренные крупинки пищи, слизь.
Если малыш испражняется слишком часто, возможно обезвоживание. Его симптомы:
- редкое мочеиспускание;
- слабость;
- сухость губ, языка.
В отдельных случаях E. coli лактозонегативные в кале у грудничка повышены, но ребенок активен, хорошо ест, прибавляет в весе. Это зависит от особенностей его иммунной системы.
Кроме нарушения числа условно патогенных E. coli, в первые дни и недели после рождения дисбактериоз может начаться из-за попадания в систему ЖКТ младенца энтеропатогенных кишечных палочек. Заразиться ими можно с молоком матери, через грязную соску, игрушки, мединструменты, плохо вымытые руки матери или медперсонала, недостаточно обработанную бутылочку.
Вопрос-ответ
Что такое лактозонегативные энтеробактерии?
Лактозонегативные энтеробактерии. Большая группа условно-патогенных бактерий большей или меньшей степени патогенности. Их количество не должно превышать (в титрах: 103 – 106).
Нужно ли лечить эшерихию коли?
Легкие и стертые формы эшерихиозов не требуют назначения антибиотиков. Если антибактериальные препараты назначены, то необходим прием эубиотиков и для коррекции дисбактериозов на протяжении не менее 7–10 дней. Симптоматическое лечение включает жаропонижающие средства и болеутоляющие препараты.
Какие антибиотики убивают E. Coli?
Антибиотики, которые могут быть эффективны против E. coli, включают ампициллин, цефалоспорины (например, цефотаксим), триметоприм-сульфаметоксазол и фторхинолоны (например, ципрофлоксацин). Однако выбор антибиотика зависит от конкретного штамма E. coli и его чувствительности, поэтому перед началом лечения важно провести антибиотикограмму.
Чем опасна бактерия E. Coli?
Кишечная палочка Escherichia coli вызывает целую группу острых инфекций, поражающих желудочно-кишечный тракт. Помимо этого, E. coli провоцирует заболевания мочевыводительных путей и становится причиной воспаления мочевого пузыря (цистита), почек (пиелонефрита) или предстательной железы (простатита).
Советы
СОВЕТ №1
Проведите анализ на лактозонегативные энтеробактерии, если у вас есть подозрения на кишечные инфекции или проблемы с пищеварением. Это поможет выявить причину недомогания и выбрать правильное лечение.
СОВЕТ №2
Обратите внимание на свой рацион. Исключите молочные продукты и продукты, содержащие лактозу, если у вас есть непереносимость. Это может помочь снизить уровень лактозонегативных энтеробактерий и улучшить общее состояние здоровья.
СОВЕТ №3
Консультируйтесь с врачом перед началом лечения. Самолечение может привести к ухудшению состояния. Специалист подберет наиболее эффективные препараты и даст рекомендации по диете.
СОВЕТ №4
Регулярно поддерживайте здоровье кишечника, включая в рацион пробиотики и пребиотики. Это поможет восстановить баланс микрофлоры и предотвратить повторное повышение уровня энтеробактерий.